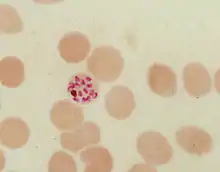

Hemozoin
Haemozoin is a disposal product formed from the digestion of blood by some blood-feeding parasites. These hematophagous organisms such as malaria parasites (Plasmodium spp.), Rhodnius and Schistosoma digest haemoglobin and release high quantities of free heme, which is the non-protein component of hemoglobin. Heme is a prosthetic group consisting of an iron atom contained in the center of a heterocyclic porphyrin ring. Free heme is toxic to cells, so the parasites convert it into an insoluble crystalline form called hemozoin. In malaria parasites, hemozoin is often called malaria pigment.

Since the formation of hemozoin is essential to the survival of these parasites, it is an attractive target for developing drugs and is much-studied in Plasmodium as a way to find drugs to treat malaria (malaria's Achilles' heel). Several currently used antimalarial drugs, such as chloroquine and mefloquine, are thought to kill malaria parasites by inhibiting haemozoin biocrystallization.
Discovery
Black-brown pigment was observed by Johann Heinrich Meckel [1] in 1847, in the blood and spleen of a person suffering from insanity.[2] However, it was not until 1849 that the presence of this pigment was connected to infection with malaria.[3] Initially, it was thought that this pigment was produced by the body in response to infection, but Charles Louis Alphonse Laveran realized in 1880 that "malaria pigment" is, instead, produced by the parasites, as they multiplied within the red blood cell.[4] The link between pigment and malaria parasites was used by Ronald Ross to identify the stages in the Plasmodium life cycle that occur within the mosquito, since, although these forms of the parasite are different in appearance to the blood stages, they still contain traces of pigment.
Later, in 1891, T. Carbone and W.H. Brown (1911) published papers linking the hemoglobin degradation with pigment production, describing the malaria pigment as a form of hematin and disproving the widely held idea that it is related to melanin. Brown observed that all melanins were bleaching rapidly with potassium permanganate, while with this reagent malarial pigment manifests not the slightest sign of a true bleach reaction.[5][6] The name "hemozoin" was proposed by Louis Westenra Sambon.[7] In the 1930s several authors identified hemozoin as a pure crystalline form of α-hematin and showed that the substance did not contain proteins within the crystals,[4] but no explanation for the solubility differences between malaria pigment and α-hematin crystals was given.
Formation
During its intraerythrocytic asexual reproduction cycle Plasmodium falciparum consumes up to 80% of the host cell hemoglobin.[8][9] The digestion of hemoglobin releases monomeric α-hematin (ferriprotoporphyrin IX). This compound is toxic, since it is a pro-oxidant and catalyzes the production of reactive oxygen species. Oxidative stress is believed to be generated during the conversion of heme (ferroprotoporphyrin) to hematin (ferriprotoporphyrin). Free hematin can also bind to and disrupt cell membranes, damaging cell structures and causing the lysis of the host erythrocyte.[10] The unique reactivity of this molecule has been demonstrated in several in vitro and in vivo experimental conditions.[11]

The malaria parasite, therefore, detoxifies the hematin, which it does by biocrystallization—converting it into insoluble and chemically inert β-hematin crystals (called hemozoin).[13][14][15] In Plasmodium the food vacuole fills with hemozoin crystals, which are about 100-200 nanometres long and each contain about 80,000 heme molecules.[4] Detoxification through biocrystallization is distinct from the detoxification process in mammals, where an enzyme called heme oxygenase instead breaks excess heme into biliverdin, iron, and carbon monoxide.[16]
Several mechanisms have been proposed for the production of hemozoin in Plasmodium, and the area is highly controversial, with membrane lipids,[17][18] histidine-rich proteins,[19] or even a combination of the two,[20] being proposed to catalyse the formation of hemozoin. Other authors have described a Heme Detoxification Protein, which is claimed to be more potent than either lipids or histidine-rich proteins.[12] It is possible that many processes contribute to the formation of hemozoin.[21] The formation of hemozoin in other blood-feeding organisms is not as well-studied as in Plasmodium.[22] However, studies on Schistosoma mansoni have revealed that this parasitic worm produces large amounts of hemozoin during its growth in the human bloodstream. Although the shapes of the crystals are different from those produced by malaria parasites,[23] chemical analysis of the pigment showed that it is made of hemozoin.[24][25] In a similar manner, the crystals formed in the gut of the kissing bug Rhodnius prolixus during digestion of the blood meal also have a unique shape, but are composed of hemozoin.[26] Hz formation in R. prolixus midgut occurs at physiologically relevant physico-chemical conditions and lipids play an important role in heme biocrystallization. Autocatalytic heme crystallization to Hz is revealed to be an inefficient process and this conversion is further reduced as the Hz concentration increases.

[27] Several other mechanisms have been developed to protect a large variety of hematophagous organisms against the toxic effects of free heme. Mosquitoes digest their blood meals extracellularly and do not produce hemozoin. Heme is retained in the peritrophic matrix, a layer of protein and polysaccharides that covers the midgut and separates gut cells from the blood bolus.[28]
Although β-hematin can be produced in assays spontaneously at low pH, the development of a simple and reliable method to measure the production of hemozoin has been difficult. This is in part due to the continued uncertainty over what molecules are involved in producing hemozoin, and partly from the difficulty in measuring the difference between aggregated or precipitated heme, and genuine hemozoin.[29] Current assays are sensitive and accurate, but require multiple washing steps so are slow and not ideal for high-throughput screening.[29] However, some screens have been performed with these assays.[30]
Structure


β-Hematin crystals are made of dimers of hematin molecules that are, in turn, joined together by hydrogen bonds to form larger structures. In these dimers, an iron-oxygen coordinate bond links the central iron of one hematin to the oxygen of the carboxylate side-chain of the adjacent hematin. These reciprocal iron–oxygen bonds are highly unusual and have not been observed in any other porphyrin dimer. β-Hematin can be either a cyclic dimer or a linear polymer,[31] a polymeric form has never been found in hemozoin, disproving the widely held idea that hemozoin is produced by the enzyme heme-polymerase.[32]
Hemozoin crystals have a distinct triclinic structure and are weakly magnetic. The difference between diamagnetic low-spin oxyhemoglobin and paramagnetic hemozoin can be used for isolation.[33][34] They also exhibit optical dichroism, meaning they absorb light more strongly along their length than across their width, enabling the automated detection of malaria.[35] Hemozoin is produced in a form that, under the action of an applied magnetic field, gives rise to an induced optical dichroism characteristic of the hemozoin concentration; and precise measurement of this induced dichroism (Magnetic circular dichroism) may be used to determine the level of malarial infection.[36]
Inhibitors

Hemozoin formation is an excellent drug target, since it is essential to malaria parasite survival and absent from the human host. The drug target hematin is host-derived and largely outside the genetic control of the parasite, which makes the development of drug resistance more difficult. Many clinically used drugs are thought to act by inhibiting the formation of hemozoin in the food vacuole.[37] This prevents the detoxification of the heme released in this compartment, and kills the parasite.[38]
The best-understood examples of such hematin biocrystallization inhibitors are quinoline drugs such as chloroquine and mefloquine. These drugs bind to both free heme and hemozoin crystals,[39] and therefore block the addition of new heme units onto the growing crystals. The small, most rapidly growing face is the face to which inhibitors are believed to bind.[40][41]
Role in pathophysiology
Hemozoin is released into the circulation during reinfection and phagocytosed in vivo and in vitro by host phagocytes and alters important functions in those cells. Most functional alterations were long-term postphagocytic effects,[42][43] including erythropoiesis inhibition shown in vitro.[44][45][46] By contrast, a powerful, short-term stimulation of oxidative burst by human monocytes was also shown to occur during phagocytosis of nHZ.[47]
References
- Janjua RM, Schultka R, Goebbel L, Pait TG, Shields CB (2010). "The legacy of Johann Friedrich Meckel the Elder (1724-1774): a 4-generation dynasty of anatomists". Neurosurgery. 66 (4): 758–770. doi:10.1227/01.NEU.0000367997.45720.A6. PMID 20305497.
- Meckel H (1847). "Ueber schwarzes Pigment in der Milz und dem Blute einer Geisteskranken". Zeitschrift für Psychiatrie. IV: 198–226.
- Virchow R (1849). "Zur pathologischen Physiologie des Bluts". Arch Pathol Anatomie Physiol Klin Med. 2 (3): 587–598. doi:10.1007/BF02114475.
- Sullivan DJ (December 2002). "Theories on malarial pigment formation and quinoline action". Int J Parasitol. 32 (13): 1645–53. doi:10.1016/S0020-7519(02)00193-5. PMID 12435449.
- Carbone T (1891). "Sulla natura chimica del pigmento malarico". G R Accad Med Torino. 39: 901–906.
- Brown WH (1911). "Malarial Pigment (So-Called Melanin): ITS Nature and Mode of Production". J Exp Med. 13 (2): 290–299. doi:10.1084/jem.13.2.290. PMC 2124860. PMID 19867409.
- Sinton JA, Ghosh BN (1934). "Studies of malarial pigment (haemozoin). Part I. Investigation of the action of solvents on haemozoin and the spectroscopical appearances observed in the solutions". Records of the Malaria Survey of India. 4: 15–42.
- Rosenthal PJ, Meshnick SR (December 1996). "Hemoglobin catabolism and iron utilization by malaria parasites". Mol Biochem Parasitol. 83 (2): 131–139. doi:10.1016/S0166-6851(96)02763-6. PMID 9027746.
- Esposito A, Tiffert T, Mauritz JM, Schlachter S, Bannister LH, Kaminski CF, Lew VL (2008). Schnur JM (ed.). "FRET Imaging of Hemoglobin Concentration in Plasmodium falciparum-Infected Red Cells". PLoS ONE. 3 (11): e3780. doi:10.1371/journal.pone.0003780. PMC 2582953. PMID 19023444.
- Fitch CD, Chevli R, Kanjananggulpan P, Dutta P, Chevli K, Chou AC (1983). "Intracellular ferriprotoporphyrin IX is a lytic agent". Blood. 62 (6): 1165–1168. doi:10.1182/blood.V62.6.1165.1165. PMID 6640106.
- Hebbel RP, Eaton JW (April 1989). "Pathobiology of heme interaction with the erythrocyte membrane". Semin Hematol. 26 (2): 136–149. PMID 2658089.
- Jani D, Nagarkatti R, Beatty W, Angel R, Slebodnick C, Andersen J, Kumar S, Rathore D (April 2008). Kim K (ed.). "HDP—A Novel Heme Detoxification Protein from the Malaria Parasite". PLoS Pathog. 4 (4): e1000053. doi:10.1371/journal.ppat.1000053. PMC 2291572. PMID 18437218.
- Fitch CD, Kanjananggulpan P (November 1987). "The state of ferriprotoporphyrin IX in malaria pigment". J Biol Chem. 262 (32): 15552–1555. PMID 3119578.
- Pagola S, Stephens PW, Bohle DS, Kosar AD, Madsen SK (March 2000). "The structure of malaria pigment beta-haematin". Nature. 404 (6775): 307–310. doi:10.1038/35005132. PMID 10749217.
- Hempelmann E (2007). "Hemozoin biocrystallization in Plasmodium falciparum and the antimalarial activity of crystallization inhibitors". Parasitol Research. 100 (4): 671–676. doi:10.1007/s00436-006-0313-x. PMID 17111179. Archived from the original on 2011-06-10.
- Kikuchi G, Yoshida T, Noguchi M (December 2005). "Heme oxygenase and heme degradation". Biochem Biophys Res Commun. 338 (1): 558–567. doi:10.1016/j.bbrc.2005.08.020. PMID 16115609.
- Pisciotta JM, Sullivan D (June 2008). "Hemozoin: Oil Versus Water". Parasitol Int. 57 (2): 89–96. doi:10.1016/j.parint.2007.09.009. PMC 2442017. PMID 18373972.
- Huy NT, Shima Y, Maeda A, Men TT, Hirayama K, Hirase A, Miyazawa A, Kamei A (2013). "Phospholipid Membrane-Mediated Hemozoin Formation: The Effects of Physical Properties and Evidence of Membrane Surrounding Hemozoin". PLoS ONE. 8 (7): e70025. doi:10.1371/journal.pone.0070025. PMC 3720957. PMID 23894579.
- Sullivan DJ, Gluzman IY, Goldberg DE (January 1996). "Plasmodium hemozoin formation mediated by histidine-rich proteins". Science. 271 (5246): 219–222. doi:10.1126/science.271.5246.219. PMID 8539625.
- Pandey AV, Babbarwal VK, Okoyeh JN, Joshi RM, Puri SK, Singh RL, Chauhan VS (September 2003). "Hemozoin formation in malaria: a two-step process involving histidine-rich proteins and lipids". Biochem Biophys Res Commun. 308 (4): 736–743. doi:10.1016/S0006-291X(03)01465-7. PMID 12927780.
- Chugh M, Sundararaman V, Kumar S, Reddy VS, Siddiqui WA, Stuart KD, Malhotra P (April 2013). "Protein complex directs hemoglobin-to-hemozoin formation in Plasmodium falciparum". Proc Natl Acad Sci U S A. 110 (14): 5392–7. doi:10.1073/pnas.1218412110. PMC 3619337. PMID 23471987.
- Egan TJ (February 2008). "Haemozoin formation". Mol Biochem Parasitol. 157 (2): 127–136. doi:10.1016/j.molbiopara.2007.11.005. PMID 18083247.
- Moore GA, Homewood CA, Gilles HM (September 1975). "A comparison of pigment from Schistosoma mansoni and Plasmodium berghei". Ann Trop Med Parasitol. 69 (3): 373–374. doi:10.1080/00034983.1975.11687021. PMID 1098591.
- Oliveira MF, d'Avila JC, Torres CR, Oliveira PL, Tempone AJ, Rumjanek FD, Braga CM, Silva JR, Dansa-Petretski M, Oliveira MA, de Souza W, Ferreira ST (November 2000). "Haemozoin in Schistosoma mansoni". Mol Biochem Parasitol. 111 (1): 217–221. doi:10.1016/S0166-6851(00)00299-1. PMID 11087932.
- Corrêa Soares JB, Menezes D, Vannier-Santos MA, Ferreira-Pereira A, Almeida GT, Venancio TM, Verjovski-Almeida S, Zishiri VK, Kuter D, Hunter R, Egan TJ, Oliveira MF (2009). Jones MK (ed.). "Interference with Hemozoin Formation Represents an Important Mechanism of Schistosomicidal Action of Antimalarial Quinoline Methanols". PLoS Negl Trop Dis. 3 (7): e477. doi:10.1371/journal.pntd.0000477. PMC 2703804. PMID 19597543.
- Oliveira MF, Kycia SW, Gomez A, Kosar AJ, Bohle DS, Hempelmann E, Menezes D, Vannier-Santos MA, Oliveira PL, Ferreira ST (2005). "Structural and morphological characterization of hemozoin produced by Schistosoma mansoni and Rhodnius prolixus". FEBS Lett. 579 (27): 6010–6016. doi:10.1016/j.febslet.2005.09.035. PMID 16229843.
- Stiebler R, Timm BL, Oliveira PL, Hearne GR, Egan TJ, Oliveira MF (2010). "On the physico-chemical and physiological requirements of hemozoin formation promoted by perimicrovillar membranes in Rhodnius prolixus midgut". Insect Biochem Mol Biol. 40 (3): 284–292. doi:10.1016/j.ibmb.2009.12.013. PMID 20060043.
- Pascoa V, Oliveira PL, Dansa-Petretski M, Silva JR, Alvarenga PH, Jacobs-Lorena M, Lemos FJ (May 2002). "Aedes aegypti peritrophic matrix and its interaction with heme during blood digestion". Insect Biochem Mol Biol. 32 (5): 517–523. doi:10.1016/S0965-1748(01)00130-8. PMID 11891128.
- Dorn A, Vippagunta SR, Matile H, Bubendorf A, Vennerstrom JL, Ridley RG (March 1998). "A comparison and analysis of several ways to promote haematin (haem) polymerisation and an assessment of its initiation in vitro". Biochem Pharmacol. 55 (6): 737–747. doi:10.1016/S0006-2952(97)00509-1. PMID 9586945.
- Tekwani BL, Walker LA (February 2005). "Targeting the hemozoin synthesis pathway for new antimalarial drug discovery: technologies for in vitro beta-hematin formation assay". Comb Chem High Throughput Screen. 8 (1): 63–79. doi:10.2174/1386207053328101. PMID 15720198.
- Lemberg R, Legge JW (1949). "Hematin compounds and bile pigments". Interscience, New York.
- Hempelmann E, Marques HM (September 1994). "Analysis of malaria pigment from Plasmodium falciparum". J Pharmacol Toxicol Methods. 32 (1): 25–30. doi:10.1016/1056-8719(94)90013-2. PMID 7833503.
- Paul F, Roath S, Melville D, Warhurst DC, Osisanya JO (1981). "Separation of malaria-infected erythrocytes from whole blood: use of a selective high-gradient magnetic separation technique". Lancet. 2 (8237): 70–71. doi:10.1016/S0140-6736(81)90414-1. PMID 6113443.
- Kim CC, Wilson EB, Derisi JL (2010). "Improved methods for magnetic purification of malaria parasites and haemozoin" (PDF). Malar J. 9 (1): 17. doi:10.1186/1475-2875-9-17. PMC 2817699. PMID 20074366.
- Mendelow BV, Lyons C, Nhlangothi P, Tana M, Munster M, Wypkema E, Liebowitz L, Marshall L, Scott S, Coetzer TL (1999). "Automated malaria detection by depolarization of laser light". Br J Haematol. 104 (3): 499–503. doi:10.1046/j.1365-2141.1999.01199.x. PMID 10086786.
- Newman DM, Heptinstall J, Matelon RJ, Savage L, Wears ML, Beddow J, Cox M, Schallig HD, Mens P (2008). "A Magneto-Optic Route toward the In Vivo Diagnosis of Malaria: Preliminary Results and Preclinical Trial Data" (PDF). Biophys J. 95 (2): 994–1000. doi:10.1529/biophysj.107.128140. PMC 2440472. PMID 18390603. Archived from the original (PDF) on 2011-07-27. Retrieved 2009-12-19.
- Ziegler J, Linck R, Wright DW (February 2001). "Heme Aggregation inhibitors: antimalarial drugs targeting an essential biomineralization process". Curr Med Chem. 8 (2): 171–89. doi:10.2174/0929867013373840. PMID 11172673.
- Coronado LM, Nadovich CT, Spadafora C (2014). "Malarial hemozoin: From target to tool". Biochim Biophys Acta. 1840 (6): 2032–2041. doi:10.1016/j.bbagen.2014.02.009. PMC 4049529. PMID 24556123.
- Sullivan DJ, Gluzman IY, Russell DG, Goldberg DE (October 1996). "On the molecular mechanism of chloroquine's antimalarial action". Proc Natl Acad Sci USA. 93 (21): 11865–70. doi:10.1073/pnas.93.21.11865. PMC 38150. PMID 8876229.
- de Villiers KA, Marques HM, Egan TJ (August 2008). "The crystal structure of halofantrine-ferriprotoporphyrin IX and the mechanism of action of arylmethanol antimalarials". J Inorg Biochem. 102 (8): 1660–1667. doi:10.1016/j.jinorgbio.2008.04.001. PMID 18508124.
- Weissbuch I, Leiserowitz L (2008). "Interplay between malaria, crystalline hemozoin formation, and antimalarial drug action and design". Chem Rev. 108 (11): 4899–4914. doi:10.1021/cr078274t. PMID 19006402.
- Arese P, Schwarzer E (1997). "Malarial pigment (haemozoin): a very active 'inert' substance". Ann Trop Med Parasitol. 91 (5): 501–516. doi:10.1080/00034989760879. PMID 9329987.
- Skorokhod OA, Alessio M, Mordmüller B, Arese P, Schwarzer E (2004). "Hemozoin (malarial pigment) inhibits differentiation and maturation of human monocyte-derived dendritic cells: a peroxisome proliferator-activated receptor-gamma-mediated effect". J Immunol. 173 (6): 4066–74. doi:10.4049/jimmunol.173.6.4066. PMID 15356156.
- Giribaldi G, Ulliers D, Schwarzer E, Roberts I, Piacibello W, Arese P (2004). "Hemozoin- and 4-hydroxynonenal-mediated inhibition of erythropoiesis. Possible role in malarial dyserythropoiesis and anemia". Haematologica. 89 (4): 492–493. PMID 15075084.
- Casals-Pascual C, Kai O, Cheung JO, Williams S, Lowe B, Nyanoti M, Williams TN, Maitland K, Molyneux M, Newton CR, Peshu N, Watt SM, Roberts DJ (2006). "Suppression of erythropoiesis in malarial anemia is associated with hemozoin in vitro and in vivo". Blood. 108 (8): 2569–77. doi:10.1182/blood-2006-05-018697. PMID 16804108.
- Skorokhod OA, Caione L, Marrocco T, Migliardi G, Barrera V, Arese P, Piacibello W, Schwarzer E (2010). "Inhibition of erythropoiesis in malaria anemia: role of hemozoin and hemozoin-generated 4-hydroxynonenal". Blood. 116 (20): 4328–37. doi:10.1182/blood-2010-03-272781. PMID 20686121. Archived from the original on 2013-06-19.
- Barrera V, Skorokhod OA, Baci D, Gremo G, Arese P, Schwarzer E (2011). "Host fibrinogen stably bound to hemozoin rapidly activates monocytes via TLR-4 and CD11b/CD18-integrin: a new paradigm of hemozoin action". Blood. 117 (21): 5674–82. doi:10.1182/blood-2010-10-312413. PMID 21460246. Archived from the original on 2013-07-09.